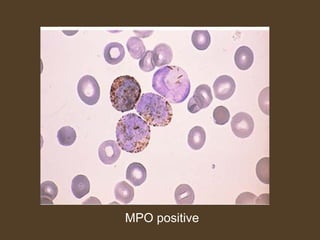
MPO positive

This document provides information on Acute Myeloid Leukemia (AML), including:
- AML is a stem cell disorder characterized by a block in differentiation of myeloid precursors.
- It has several predisposing factors such as Down syndrome and exposure to radiation or chemicals.
- Diagnosis involves evaluation of blood counts, identification of blasts in blood and bone marrow, immunophenotyping of blasts, and cytogenetic/molecular testing.
- Several classification systems exist including the French-American-British (FAB) system and the current World Health Organization (WHO) system.
















![Physical Examination
Ecchymosis and oozing from IV sites (DIC, possible acute
promyelocytic leukemia)
Fever and tachycardia (signs of infection)
Papilledema, retinal infiltrates, cranial nerve abnormalities (CNS
leukemia)
Poor dentition, dental abscesses
Gum hypertrophy (leukemic infiltration)(M4)
Skin infiltration or nodules (leukemia infiltration)(M4)
Lymphadenopathy, splenomegaly, hepatosplenomegaly
Back pain, lower extremity weakness [spinal granulocytic
sarcoma, most likely in t(8;21) patients]](https://image.slidesharecdn.com/acutemyeloidleukemia-141212110030-conversion-gate02/85/Acute-myeloid-leukemia-17-320.jpg)